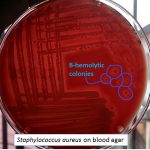
Beta hemolytic colony of Staphylococcus aureus on Blood agar

Collection Group: Clinical Bacteriology
Clostridium Gram Stain: Introduction, Requirements, Procedure, Result and Interpretation
 Clostridium Gram Stain Clostridium species in gram stain showing gram-positive rods...
Clostridium Gram Stain Clostridium species in gram stain showing gram-positive rods...
Beta hemolytic colony of Staphylococcus aureus on Blood agar and this organism related informations
Beta hemolytic colony of Staphylococcus aureus on Blood Agar Beta...
Beta hemolytic colony of Staphylococcus aureus on Blood Agar Beta...
Multiple Drug Resistance (MDR) Microorganisms: Introduction, Definition, Types, Resistance Mechanism and Prevention
 Multiple Drug Resistance (MDR) Introduction Multiple drug resistance (MDR) bacteria as...
Multiple Drug Resistance (MDR) Introduction Multiple drug resistance (MDR) bacteria as...
